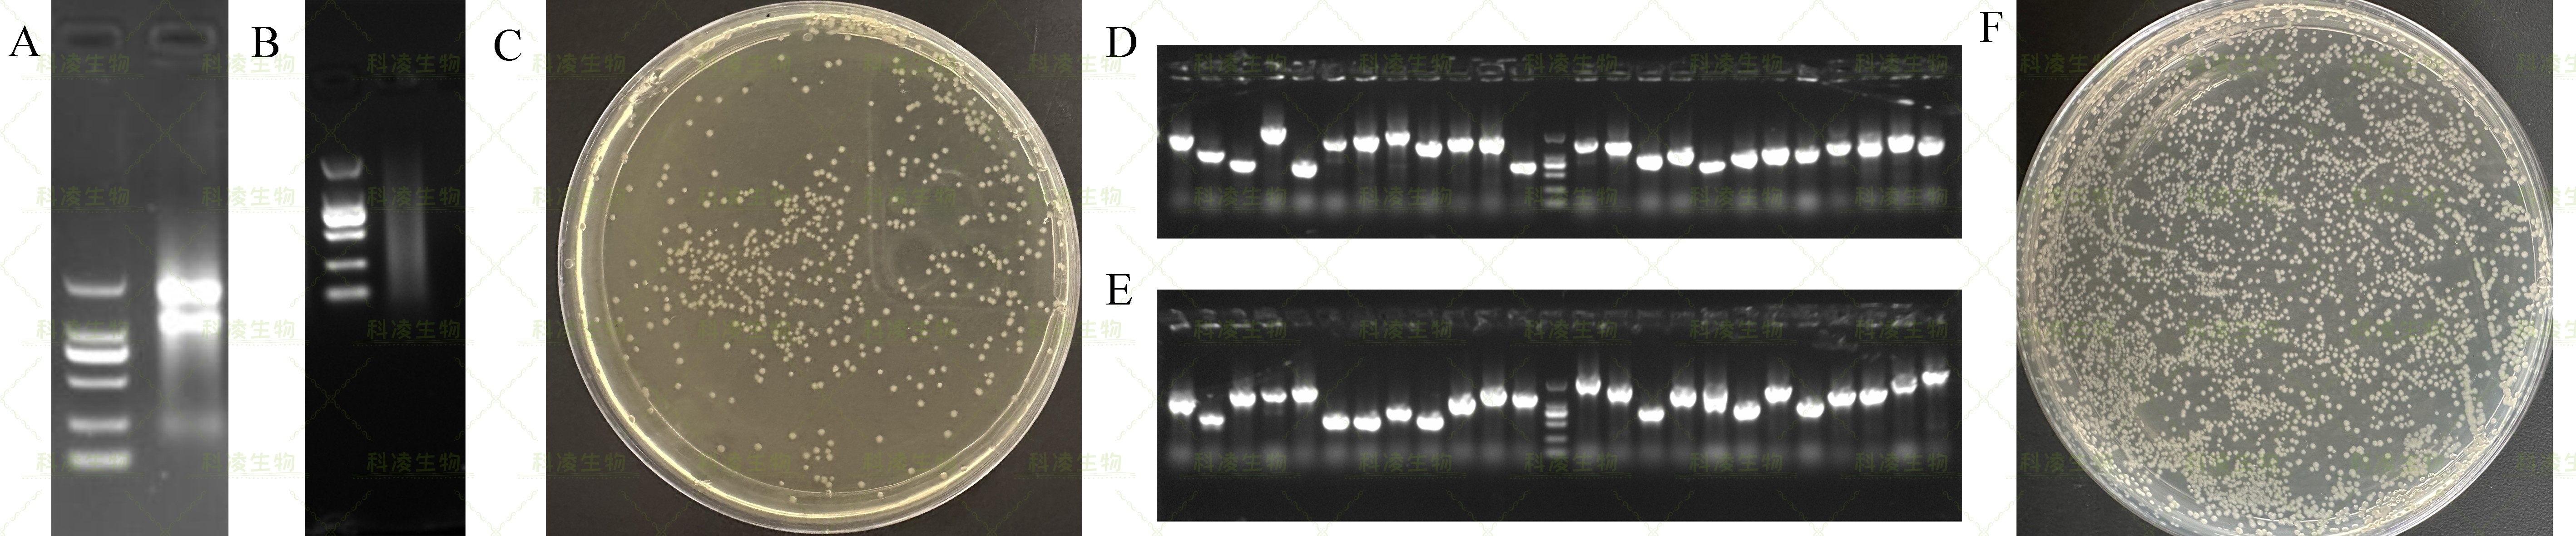
13酵母建库.jpg 13酵母建库.jpg

技术服务
技术服务
转录因子通常由DNA结合结构域(DNA—binding domain,BD)和转录激活结构域(activation domain,AD)组成。基于此,酵母单双杂交系统将目的物种的基因构建至pGADT7质粒中,从而形成文库用于后续互作蛋白或者结合启动子的筛选。Gateway 重组技术是由 Invitrogen开发并用于构建酵母文库,其原理是利用细菌噬菌体 λ 的重组系统,将特异性的重组序列加到 DNA 片段的两端并实现不同载体间的转移。酵母双杂交原理是Gal4 转录因子的 DNA 结合域和转录激活域可以分开表达,当二者在物理空间上靠近时可以表现出完整的转录因子活性。把目的蛋白分别与 BD和AD 融合表达,当目的蛋白发生互作时,融合的BD和AD 蛋白相互靠近而表现出完整的转录因子功能,从而激活下游基因的表达。酵母单杂交是在酵母双杂交的基础上发展而来的一种研究蛋白-DNA相互作用的工具。原理图如下:

1、筛选与目的蛋白互作的未知蛋白;
2、筛选结合目的启动子的未知蛋白。
1、自研不同植物及多糖多酚RNA提取试剂盒,保证RNA高提取量及完整性;
2、高质量的mRNA纯化技术,保证后续高库容(1*107次方);
3、Gateway构建方法,确保文库基因均一化,且无冗余;
4、文库构建过程无PCR过程确保平均插入片段超过1kb。
建库:咨询下单—植物材料寄送—文库构建—质检—结果交付;
筛库:诱饵确认—载体构建—文库筛选-结果交付。
标准实验报告,包括实验步骤与结果;
建库产品:1、初次级文库甘油菌各 4 ml;2、初次级文库质粒各200 μg;
筛库:50个阳性克隆的PCR测序,超过50个克隆部分为40元/克隆测序;
建库和筛库过程的图片(单反拍照)。
建库实验组织样本需要干冰寄送,且质量不少于10g;
载体需要新鲜或甘油菌液体积大于0.5 ml,冰袋运输;
质粒 DNA 体积大于20 μl,浓度不低于30ng/μl,,且主带明显无降解;
提供测序结果以及抗性;
如需我司构建载体,要求详见载体构建。
结果初析:水稻叶片RNA提取后电泳检测(A),显示RNA的28S和18S条带清晰,说明样品总RNA的浓度较高且完整性良好,可用于后续mRNA纯化。mRNA提取纯化后电泳检测(B),显示mRNA呈现弥散的条带并集中在500-2000bp处,说明mRNA无降解,可用于后续文库片段的制备。初级文库质粒制备后转化大肠杆菌并涂板用于库容计算(C),显示库容约4.5×106cfu/mL,说明文库基本确保了样本中表达信息(mRNA)的完整性。初级和次级文库插入片段大小检测(D,E),显示文库插入片段阳性率超过95%并且插入片段均超过750bp。次级文库质粒制备后转化大肠杆菌并涂板用于库容计算(F),显示库容约7.5×106cfu/mL。